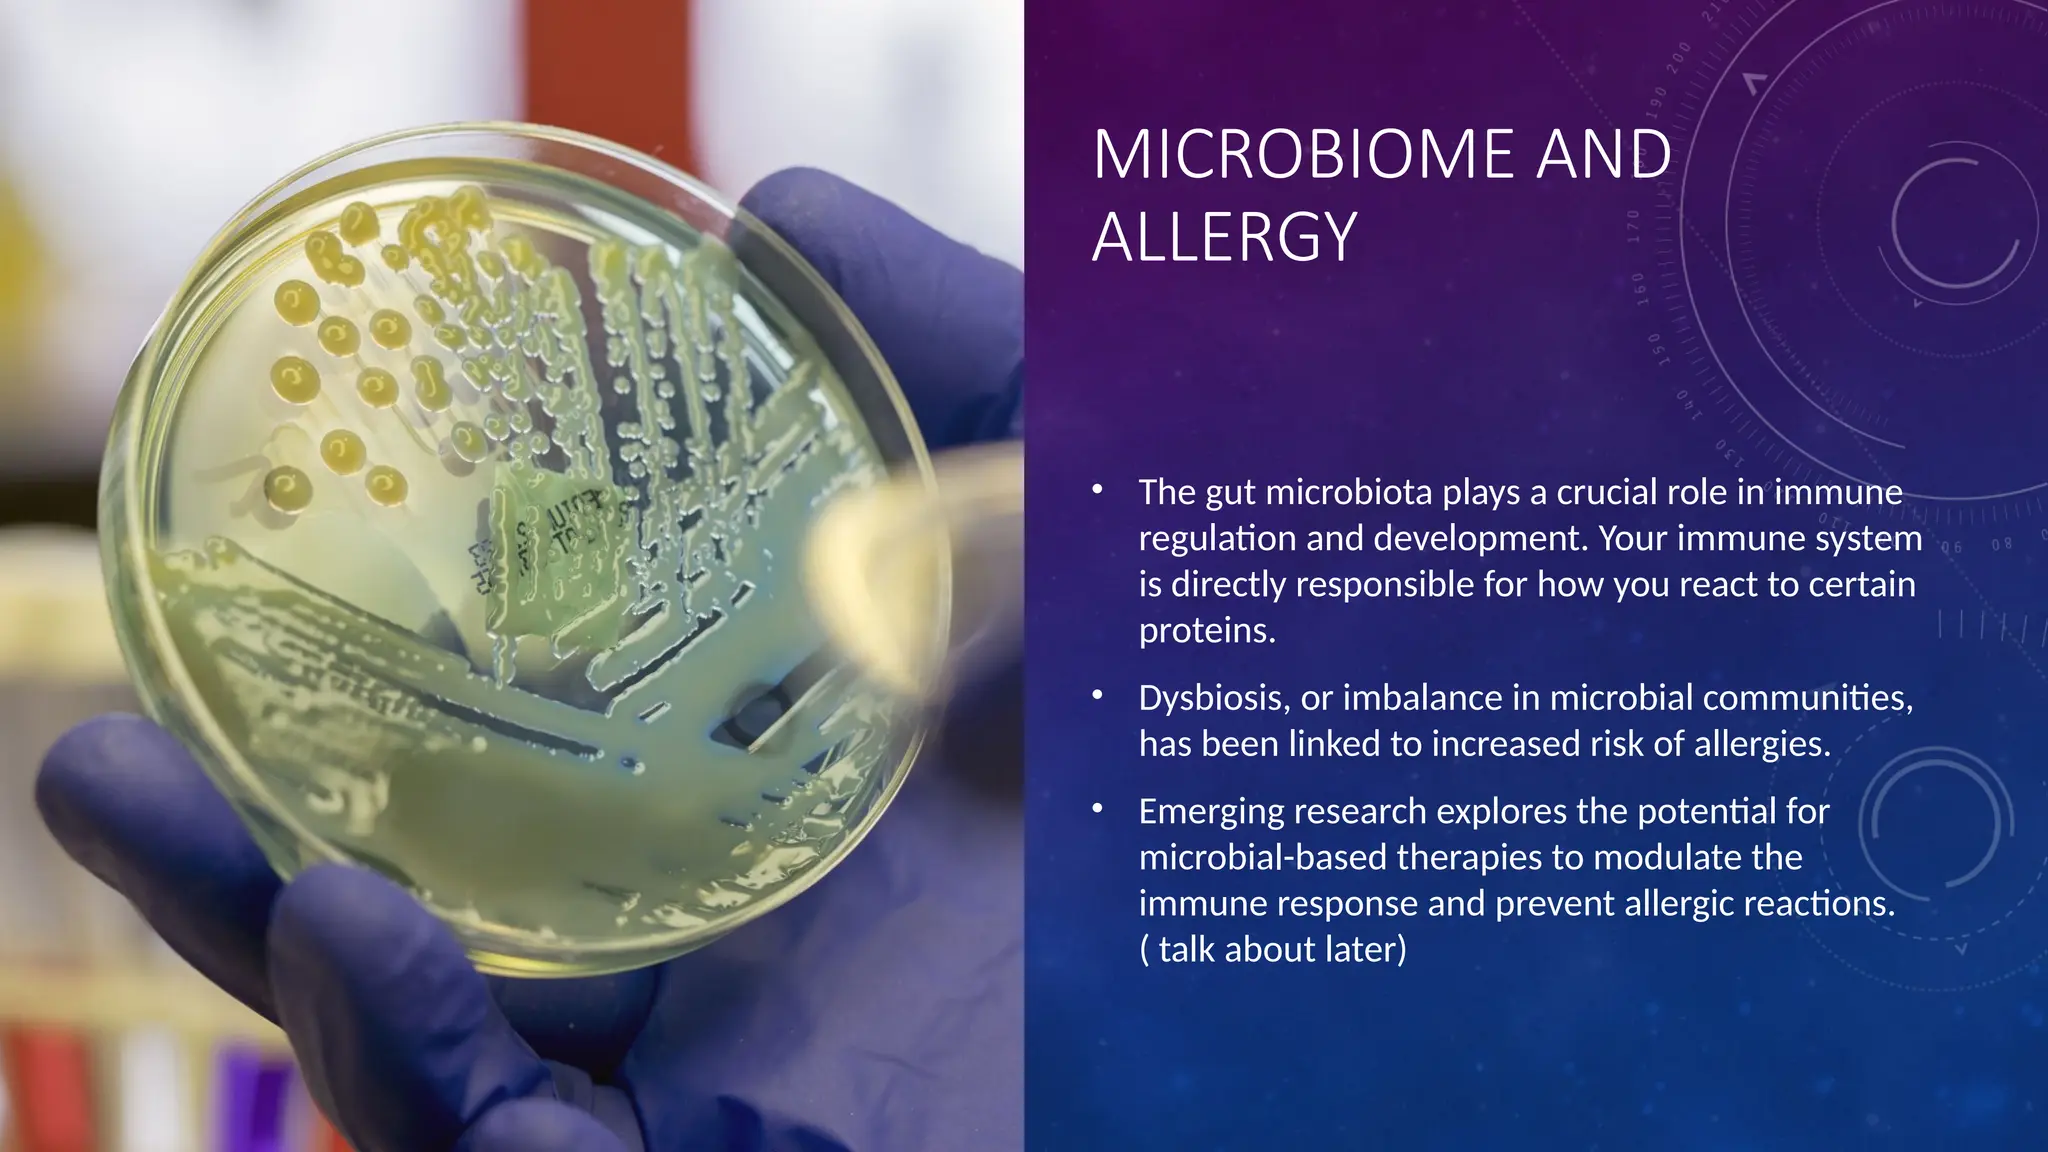
MICROBIOME AND
ALLERGY
• The gut microbiota plays a crucial role in immune
regulation and development. Your immune system
is directly responsible for how you react to certain
proteins.
• Dysbiosis, or imbalance in microbial communities,
has been linked to increased risk of allergies.
• Emerging research explores the potential for
microbial-based therapies to modulate the
immune response and prevent allergic reactions.
( talk about later)

This document explores the complexities of allergies, detailing their physiological mechanisms, common allergens, and genetic and environmental factors that contribute to their development. It discusses the impact of allergies on quality of life and the importance of new diagnostic tools and management strategies, including immunotherapy and allergen avoidance techniques. The document emphasizes ongoing research into the microbiome's role in allergy susceptibility and the need for comprehensive strategies to mitigate allergic reactions.